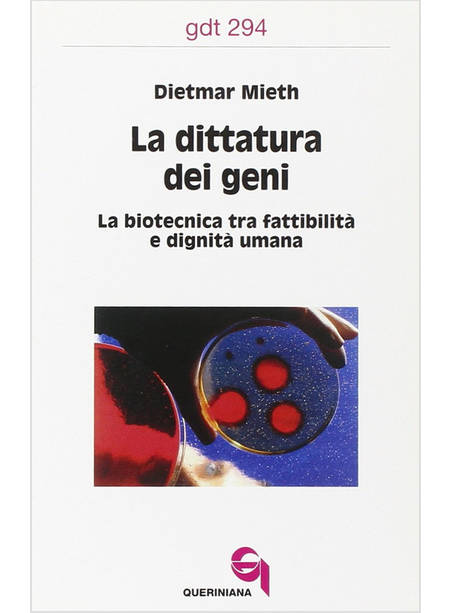

DITTATURA DEI GENI
Autore: MIETH DIETMAR
Editore: QUERINIANA
Data di pubblicazione: Febbraio 2003
Collana: GDT
Codice: 9788839907943
Dimensioni: 19,5 cm x 12,3 cm
Peso: 210 g
Pagine: 192
DISPONIBILE SUBITO
Spedizione gratis per ordini sopra i 69,99 €
(per pagamenti effettuati con carta di credito o PayPal.)
Descrizione di "DITTATURA DEI GENI"
La ricerca biomedica avanza, il progresso segue il modello della genetica: l'autore mostra dove stanno i problemi morali, quando il futuro deventa fantascienza e si rinuncia ai valori essenziali.